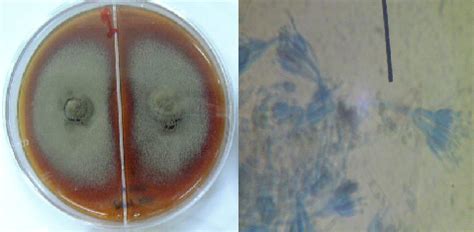
lengkung langit koloni belanda koloni bakteri  beri beri

Jika kamu sedang mencari Koloni, maka anda berada di halaman yang tepat. Kami menyediakan aneka Koloni yang bisa anda pesan online. Silakan hubungi kami via +6282245078486, jangan lupa sertakan juka gambar yang diinginkan.
Kami mengirim paket Koloni melalui berbagai ekspedisi, misalnya JNE, JNT, POS, dll. Kami juga menerima pembayaran via BCA/Mandiri/dll. Pengiriman biasanya tidak sampai seminggu sudah sampai dan kami sertakan pula nomor resi yang bisa digunakan untuk tracking barang secara online.

Tidak hanya Koloni, anda juga bisa melihat gambar lain seperti
Tælle Lysbord,
Contoh Jurnal,
Kandang Kambing,
Escherichia Coli,
PT SPV Purwakarta,
Ternak Kenari,
Lebah Madu Klanceng,
Kandang Domba,
Eatery Logo,
and Madu Kelulut.
Berbagai Contoh Koloni
Berikut kami sertakan berbagai contoh gambar untuk Koloni, silakan save gambar di bawah dengan klik tombol pesan, anda akan kami arahkan pemesanan via WA ke +6282245078486.
 768×1024
768×1024
morfologi koloni bakteri karakteristik contoh jenis koloni utama
Order Sekarang
 1000×700
1000×700
arti kata koloni jaringan kamus besar bahasa indonesia kbbi
Order Sekarang
 1080×1080
1080×1080
jobs pt koloni bersama indonesia february glints
Order Sekarang
 360×360
360×360
struktur koloni gambar png file vektor psd gratis pngtree
Order Sekarang
 469×612
469×612
koloni ilustrasi grafik vektor clip art bebas royalti istock
Order Sekarang
 0 x 0
0 x 0
bangunan simulasi koloni mars dibangun dubai dafundacom
Order Sekarang
 612×241
612×241
koloni foto stok potret gambar bebas royalti istock
Order Sekarang
 720×720
720×720
penerbit koloni membuka lowongan pekerjaan kaori nusantara
Order Sekarang
 665×574
665×574
mikrobiologi tehnisi kesehatan morfologi koloni
Order Sekarang
 730×410
730×410
ilmuwan mulai memikirkan membuat koloni bawah tanah
Order Sekarang
 612×408
612×408
koloni foto foto foto stok potret gambar bebas royalti istock
Order Sekarang
 1074×795
1074×795
mengenal koloni bakteri ciri ciri sifat bentuk koloni bakteri
Order Sekarang
 508×339
508×339
koloni bakteri foto stok gambar bacillus subtilis
Order Sekarang
479×235
479×235
lengkung langit koloni belanda koloni bakteri beri beri
Order Sekarang
Temukan solusi terbaik untuk kenyamanan ruang Anda dengan Koloni! Produk peredam suara dan panas ini menawarkan performa maksimal dengan harga yang terjangkau. Dapatkan kualitas unggul tanpa menguras kantong, dan nikmati suasana tenang serta sejuk di setiap sudut rumah atau kantor Anda. Pilih Koloni – pilihan cerdas untuk investasi jangka panjang!
Maaf, tidak ada yang cocok dengan kriteria yang Anda cari.
Apa yang ingin Anda lakukan?
« kembali ke Beranda atau gunakan kotak pencarian dibawah ini untuk mulai penelusuran baru.









